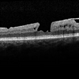

-
 By Manish Nagpal, MD, FRCS (UK), FASRS
By Manish Nagpal, MD, FRCS (UK), FASRS
Retina Foundation - Uploaded on Feb 7, 2017.
- Last modified by Caroline Bozell on Feb 7, 2017.
- Rating
- Appears in
- Miscellaneous
- Condition/keywords
- macular pseudohole
- Photographer
- Pooja Barot
- Imaging device
- Fundus camera
- Description
- Fundus appearance of a macular hole is basically a small central break in the hyaloid mimicking a macular hole. The OCT in the next picture depicts the break in the hyaloid.


 Initializing download.
Initializing download.